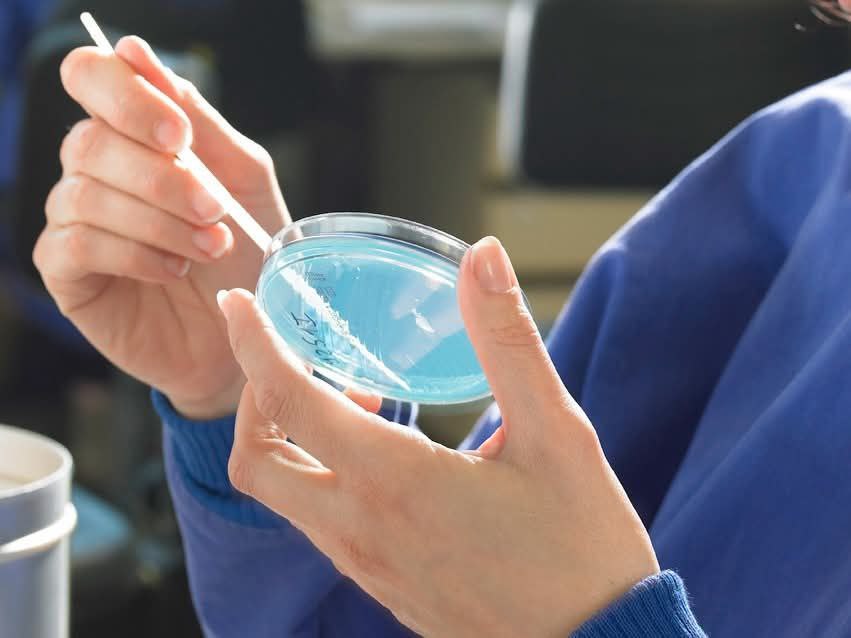
Laboratory photo 5

Aloom Alahia
Exclusive agent of Bioscientia Institute for Diagnostic Medicine GmbH in Tripoli, Libya, delivering German-grade medical and laboratory diagnostics with uncompromising precision.
About Aloom Alahia
Bioscientia — Germany
Bioscientia Institute for Diagnostic Medicine GmbH is a leading German diagnostics organization headquartered in Ingelheim, Germany, renowned for scientific rigor, advanced laboratory infrastructure, and a legacy of research excellence.
Headquarters
Ingelheim, Germany — approximately 40 km from Frankfurt International Airport
Founded
1970
Group Membership
Member of Sonic Healthcare Group
Regional Presence
Strong foothold in the Middle East since 1982
Scale & Operations
- One of the largest reference laboratories in Europe
- ~2,800 professionals (scientists, doctors, medical assistants, technicians)
- ~835 laboratory tours per day; sample collection up to 100–200 km/day
- Processing up to 100,000 patients per day
Accreditations & Certifications
Core Values
- Medicine is first
- Special focus on education and training
- Comprehensive diagnostic services
- Deep analytical insight from laboratory data
Leadership
Prof. Dr. med. Oliver Hahner, MBA — CEO & Managing Director, Bioscientia GmbH
Jad Ayoub, MBA, eSCP — Managing Director, Bioscientia International
Products & Services
Comprehensive panels for hematology, biochemistry, immunology, and infectious disease testing.
Advanced molecular diagnostics, carrier screening, and personalized medicine insights.
Expert histopathology and cytology supported by German reference laboratories.
Temperature-controlled logistics, result delivery, and continuous scientific support.
Gallery